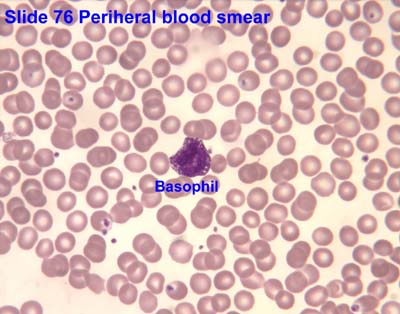

Home ⇨ Blood components under microscope
Blood Components Under Microscope
Get Blood components under microscope For Android - Check out this fantastic collection of Best HD wallpapers, with the Best HD background images for your desktop, phone or tablet. Today i will share Blood components under microscope wallpaper. The best creative wallpapers are not cheap photos, but are works of art in their own right. Wallpapers can be creative, inspiring, gorgeous.

Download Blood components under microscope Desktop Wallpaper Free































/red_blood_cells_1-57b20c583df78cd39c2f8e15.jpg)












/white_blood_cells-581115905f9b58564c7a051a-5c45e6c04cedfd0001877a06.jpg)













































